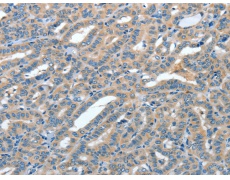
一抗

中文名稱:兔抗ANGPT1多克隆抗體
英文名稱: Anti-ANGPT1 rabbit polyclonal antibody
別 名: AGP1; AGPT; ANG1
抗 原: ANGPT1
宿 主: Rabbit
相關(guān)類(lèi)別: 一抗
反應(yīng)種屬: Human, Mouse, Rat
標(biāo) 記 物: Unconjugate
克隆類(lèi)型: rabbit polyclonal
|
Background: |
This gene encodes a secreted glycoprotein that belongs to the angiopoietin family. Members of this family play important roles in vascular development and angiogenesis. All angiopoietins bind with similar affinity to an endothelial cell-specific tyrosine-protein kinase receptor. The protein encoded by this gene is a secreted glycoprotein that activates the receptor by inducing its tyrosine phosphorylation. It plays a critical role in mediating reciprocal interactions between the endothelium and surrounding matrix and mesenchyme and inhibits endothelial permeability. The protein also contributes to blood vessel maturation and stability, and may be involved in early development of the heart. Alternative splicing results in multiple transcript variants encoding distinct isoforms. |
|
Applications: |
ELISA, WB, IHC |
|
Name of antibody: |
ANGPT1 |
|
Immunogen: |
Full length fusion protein |
|
Full name: |
angiopoietin 1 |
|
Synonyms: |
AGP1; AGPT; ANG1 |
|
SwissProt: |
Q15389 |
|
ELISA Recommended dilution: |
2000-5000 |
|
IHC positive control: |
Human thyroid cancer and human colon cancer |
|
IHC Recommend dilution: |
50-200 |
|
WB Predicted band size: |
58 kDa |
|
WB Positive control: |
Human prostate tissue and testis tissue lysates |
|
WB Recommended dilution: |
500-2000 |


 購(gòu)物車(chē)
購(gòu)物車(chē) 幫助
幫助
 021-54845833/15800441009
021-54845833/15800441009